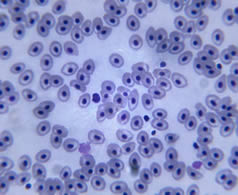

Ácaros
Son una subclase de arácnidos que tienen un tamaño entre 0,2 y 0,5 milímetros y pueblan nuestras casas. ¡En un solo colchón podríamos encontrar más de 2 millones!
Antes de la invención del microscopio, la división que se hacía de los seres vivos tenía en cuenta las características macroscópicas, es decir aquellas que se podían distinguir a simple vista. Si bien los naturalistas tenían algunos indicios sobre la existencia de formas de vida microscópica, no fue sino hasta que se creó el microscopio en 1590 que se abrió la puerta hacia un nuevo mundo: el de los microorganismos.
HISTORIA DEL MICROSCOPIO
El microscopio es un instrumento que permite observar objetos que son demasiado pequeños para ser observados a simple vista. Fue inventado en el año 1590 por un fabricante de anteojos holandés llamado Zaccharias Janssen. En 1655, el inglés Robert Hooke creó el primer microscopio compuesto. Este microscopio utilizaba dos sistemas de lentes, las lentes oculares para visualizar, y las lentes objetivos para aumentar la imagen del objeto observado. Publicó además el primer libro en el que se describían las observaciones de varios microorganismos en su microscopio.
En 1673, el holandés Antoni Van Leeuwenhoek fabricó sus propios microscopios simples, que lo llevaron al descubrimiento de los glóbulos rojos, así como también de las bacterias, los protistas y el esperma humano. En la segunda mitad del siglo XIX las mejoras en los microscopios fueron avanzando hasta que a principios de los años 1930 se había alcanzado el límite técnico para los microscopios ópticos.
 En su libro, Robert Hooke llamó a los numerosos compartimientos que componían a un ser vivo como “células”.
En su libro, Robert Hooke llamó a los numerosos compartimientos que componían a un ser vivo como “células”.
En 1931 en Alemania, Max Knoll y Ernst Ruka desarrollaron un nuevo tipo de microscopio que utilizaba un haz de electrones en lugar de luz para enfocar la muestra. A este microscopio se lo llamó microscopio electrónico de transmisión y alcanza un aumento muchísimo mayor que el del microscopio óptico. Posteriormente, en 1937 se desarrolló el microscopio electrónico de barrido.


Nombre
Antoni Van Leeuwenhoek
Fecha de nacimiento
/ fallecimiento
1632 – 1723
Lugar de nacimiento
Delft, Países Bajos
Ocupación
Comerciante y científico
Fue reconocido por sus trabajos y avances en la microscopía. Desde 1674 hasta su muerte realizó numerosos descubrimientos, entre ellos el de los glóbulos rojos, introdujo mejoras en la fabricación de microscopios y fue uno de los precursores de la Biología experimental, la Biología celular y la Microbiología.
 En su libro, Robert Hooke llamó a los numerosos compartimientos que componían a un ser vivo como “células”.
En su libro, Robert Hooke llamó a los numerosos compartimientos que componían a un ser vivo como “células”.
Las personas que viven en regiones de altitudes elevadas tienen más glóbulos rojos debido al bajo nivel de oxígeno en su entorno.
 Microscopio creado por Leeuwenhoek.
Microscopio creado por Leeuwenhoek.
La nieve está compuesta por copos de nieve, que a su vez están constituidos por cristales de agua producto de la condensación del vapor de agua y hielo sin pasar por un estado intermedio. Estos cristales suelen adquirir diversas formas, descubre más sobre estas bellas estructuras microscópicas en la siguiente infografía.

El orificio central de la platina permite el paso de los rayos procedentes de la fuente de iluminación situada por debajo. El condensador y el diafragma debajo de la platina regulan la cantidad y la concentración de los haces de luz. Estos haces, al chocar con la muestra y al pasar por los lentes de los objetivos y el ocular, aumentan el tamaño de la imagen de la muestra.
TIPOS DE MICROSCOPIOS
Antes de describir cada uno de ellos haremos una distinción entre los dos grupos de microscopios que existen:
• Los microscopios ópticos: utilizan la luz para enfocar la muestra.
• Los microscopios electrónicos: utilizan un haz de electrones para enfocar la muestra.
EL MICROSCOPIO ÓPTICO Y SUS PARTES
Un microscopio óptico es aquel que se vale del uso de lentes y el paso de luz a través de ellos para aumentar el tamaño del objeto que se quiere observar o estudiar. También es llamado microscopio de campo claro.
a) Ocular: lente situada cerca del ojo del observador. Capta y amplía la imagen formada en los objetivos.
b) Objetivos: lentes situadas en el revólver. Pueden ser entre uno y cuatro lentes que amplían la imagen en diferentes tamaños. Es un elemento fundamental que permite ver a través de los oculares.
c) Condensador: lente que concentra los rayos luminosos sobre la muestra a observar.
d) Diafragma: regula la cantidad de luz que llega al condensador.
e) Foco: fuente de luz que dirige los rayos luminosos hacia el condensador.
f) Tubo: es la cámara oscura que porta el ocular y los objetivos. Puede estar unida al brazo mediante una cremallera para permitir el enfoque.
g) Revólver: es el que porta los objetivos de diferentes aumentos y rota para poder utilizar uno u otro dependiendo del tamaño que posea la muestra.
h) Platina: Es una plataforma horizontal con un orificio central, sobre la que se apoya la preparación que se quiere observar. Dos pinzas sirven para retener el portaobjetos sobre la platina.
i) Tornillos macro y micrométrico: son tornillos que ayudan a enfocar. Se encuentran sobre la platina.
j) Brazo: estructura que sujeta el tubo, la platina y los tornillos de enfoque asociados al tubo o a la platina. La unión con la base puede ser articulada o fija.
k) Base o pie: parte inferior del microscopio que permite que éste se mantenga de pie.

En el microscopio óptico podemos ver células y estructuras celulares internas como las mitocondrias.
MICROSCOPIOS ELECTRÓNICOS
Un microscopio electrónico utiliza electrones en lugar de luz visible para formar imágenes de objetos muy pequeños. Estos microscopios alcanzan amplificaciones mucho mayores que las generadas por microscopios ópticos, debido a las propiedades de las ondas que producen los electrones.
Microscopio electrónico de transmisión
Los microscopios electrónicos de transmisión (MET) pueden aumentar la imagen de un objeto hasta un millón de veces. El funcionamiento del MET se da mediante la emisión de un haz de electrones hacia el objeto cuya imagen se desea aumentar. Una parte de los electrones rebotan o son absorbidos por el objeto y otros lo atraviesan formando la imagen aumentada de la muestra. Para utilizar un MET la muestra debe cortarse capas finas con un instrumento especial llamado micrótomo.
Microscopio electrónico de barrido
El microscopio electrónico de barrido (MEB) se utiliza para ver objetos en tres dimensiones. La muestra que se desea observar es recubierta con una capa de metal delgado, y luego es barrida con electrones enviados desde un cañón que posee el MEB. Un detector mide la cantidad de electrones en la zona de muestra y proyecta sobre una pantalla de TV figuras en tres dimensiones. Permite obtener imágenes de gran resolución en materiales pétreos, metálicos y orgánicos.
EL MUNDO MICROSCÓPICO
¿De qué hablamos cuando decimos que algo es microscópico? Aunque la vida transcurre delante de nuestros ojos en su forma macroscópica, es decir, visible a simple vista, también hay un mundo que escapa al sentido de la vista. Afortunadamente, la invención del microscopio y los avances en la tecnología óptica nos han permitido acercarnos a este submundo oculto a nuestros ojos.
El ojo humano es capaz de ver, en el mejor de los casos, objetos que están entre 0.1 y 0.2 mm. Una célula de nuestro cuerpo mide aproximadamente 10 veces menos que la mínima medida que nuestro ojo alcanza a percibir y una bacteria cien veces menos. Esto quiere decir que durante mucho tiempo hasta que se inventó el primer microscopio el mundo era sólo macroscópico.
Gracias al invento de la microscopía no sólo sabemos la forma y el tamaño de objetos tan pequeños como un grano de arena, sino que también descubrimos nuevas formas de vida como las bacterias, los protistas y algunos hongos microscópicos. También se pudo avanzar en estudios de medicina ya que el desarrollo de la microscopía permitió conocer más acerca de los tejidos y células que componen el cuerpo humano. Incluso los avances en microscopia permitieron el desarrollo de nuevas tecnologías de punta como la nanotecnología.

Partes de un microscopio electrónico.
 El procesamiento de las muestras en el MET es mucho más complejo que en el de barrido, ya que se busca aumentar la imagen de estructuras internas de los organismos y no su forma externa.
El procesamiento de las muestras en el MET es mucho más complejo que en el de barrido, ya que se busca aumentar la imagen de estructuras internas de los organismos y no su forma externa.
 El MEB tiene una capacidad similar a la del MET, por lo que es posible ver organismos tan chicos como los que vemos en las imágenes.
El MEB tiene una capacidad similar a la del MET, por lo que es posible ver organismos tan chicos como los que vemos en las imágenes.
 El polvo que barremos en nuestra casa está lleno de objetos microscópicos y organismos vivos, como ácaros, bacterias y hogos.
El polvo que barremos en nuestra casa está lleno de objetos microscópicos y organismos vivos, como ácaros, bacterias y hogos.

